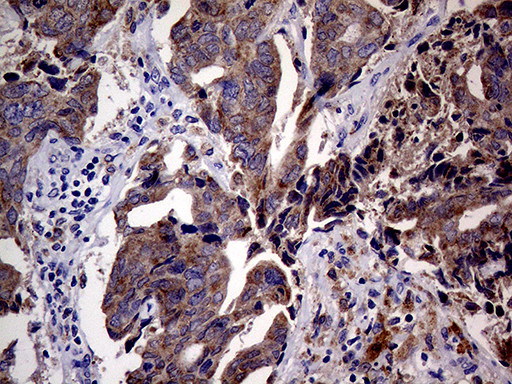
CDKN2A Antibody in Immunohistochemistry (Paraffin) (IHC (P))

Search
OriGene
CDKN2A Monoclonal Antibody (OTI11A6), TrueMAB™
{{$productOrderCtrl.translations['antibody.pdp.commerceCard.promotion.promotions']}}
{{$productOrderCtrl.translations['antibody.pdp.commerceCard.promotion.viewpromo']}}
{{$productOrderCtrl.translations['antibody.pdp.commerceCard.promotion.promocode']}}: {{promo.promoCode}} {{promo.promoTitle}} {{promo.promoDescription}}. {{$productOrderCtrl.translations['antibody.pdp.commerceCard.promotion.learnmore']}}
产品信息
TA809885
种属反应
宿主/亚型
分类
类型
克隆号
抗原
偶联物
形式
浓度
规格
纯化类型
保存液
内含物
保存条件
运输条件
靶标信息
This gene generates several transcript variants which differ in their first exons. At least three alternatively spliced variants encoding distinct proteins have been reported, two of which encode structurally related isoforms known to function as inhibitors of CDK4 kinase. The remaining transcript includes an alternate first exon located 20 Kb upstream of the remainder of the gene; this transcript contains an alternate open reading frame (ARF) that specifies a protein which is structurally unrelated to the products of the other variants. This ARF product functions as a stabilizer of the tumor suppressor protein p53 as it can interact with, and sequester, the E3 ubiquitin-protein ligase MDM2, a protein responsible for the degradation of p53. In spite of the structural and functional differences, the CDK inhibitor isoforms and the ARF product encoded by this gene, through the regulatory roles of CDK4 and p53 in cell cycle G1 progression, share a common functionality in cell cycle G1 control. This gene is frequently mutated or deleted in a wide variety of tumors, and is known to be an important tumor suppressor gene.
仅用于科研。不用于诊断过程。未经明确授权不得转售。
篇参考文献 (0)
生物信息学
蛋白别名: a frameshift between exon 1 (0.18) and exon 2 changed the ORF of p16INK4 gene.; Alternative reading frame; ARF; CDK4 inhibitor p16 INK4; CDK4 inhibitor p16-INK4; CDK4I; CDKN2A/ARF Intron 2 lncRNA; cell cycle negative regulator beta; Cyclin dependent kinase 4 inhibitor A; Cyclin-dependent kinase 4 inhibitor A; Cyclin-dependent kinase inhibitor 2A; cyclin-dependent kinase inhibitor 2A (melanoma, p16, inhibits CDK4); HGNC:1787; hypothetical 18.1 kDa protein from longest open reading frame; inhibitor of cdk4 A; inhibits CDK4; isoforms 1/2/3; Melanoma p16 inhibits CDK4; MTS-1; Multiple tumor suppressor 1; multiple tumour suppressor 1; P14 P16; p14ARF; p16; p16 gamma; p16-INK4; p16-INK4a; P19 TP16; Tumor suppressor ARF
基因别名: ARF; CAI2; CDK4I; CDKN2; CDKN2A; CMM2; INK4; INK4A; MLM; MTS-1; MTS1; P14; P14ARF; P16; P16-INK4A; P16INK4; P16INK4A; P19; P19ARF; TP16
UniProt ID: (Human) P42771
Entrez Gene ID: (Human) 1029